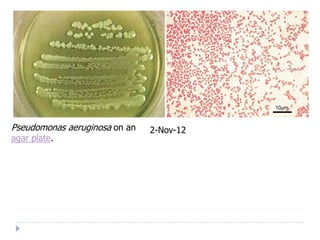
Pseudomonas aeruginosa on an   2-Nov-12
agar plate.

A previously healthy 32-year-old male presented with a 2-day history of fever, chills, productive cough, dyspnea, and chest pain. On examination, he had tachycardia, tachypnea, and reduced breath sounds with crackles on the left side of his chest. He likely has pneumonia based on his symptoms and physical exam findings of reduced breath sounds and crackles.